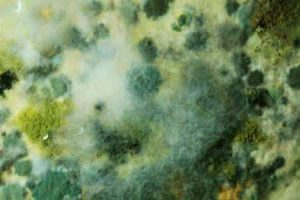

为什么一到雨季就容易长霉
为什么一到雨季东西就容易长霉
霉菌芽孢在室内外空气中总是存在的,其含量的多少与季节及室外空气状况相关。此外,霉菌的生长扩散,需要良好的周边环境,包括:能够附着的建筑表面,氧气,合适的温度,营养物质,湿气或自由水。此外,pH值,日光,表面粗糙度,生物体的相互作用,暴露时间等都能影响霉菌的生长 。
霉菌生长的条件
温度。温度对霉菌的繁殖有重要的影响,不同种类的霉菌其最适温度是不一样的,大多数霉菌繁殖最适宜的温度为25~30℃,在0℃以下或30℃以上,不能生长或生长力减弱。如黄曲霉的最低繁殖温度范围是6-8℃,最高繁殖温度是44~46℃,最适生长温度37℃左右。但产毒温度则不一样,略低于生长最适温度,如黄曲霉的最适产毒温度为28-32℃。
湿度。大多数霉菌在相对湿度约65%以上的环境才能生长。较低的相对湿度能够延迟霉孢发芽,减缓霉菌生长速度。通常相对湿度达到75%以上是霉菌最容易生长的环境,特别是到了梅雨季节,空气中的湿度会达到一个很适合霉菌生长的条件,皮革、纺织品、木材等物料含有的水分亦有利于霉菌繁殖。
营养源:霉菌也是生物的一种,跟人一样是需要食物的,特别是皮革,胶水等物质中含有的一些油脂,淀粉等营养物质,是霉菌喜欢的食物。所以往往发霉的产品总是一些营养物质含量高的产品
如果您想了解霉菌知识,或者相对产品进行防霉护理,可咨询我司工作人员:15602200485 艾浩尔防霉专家
Comments are closed.